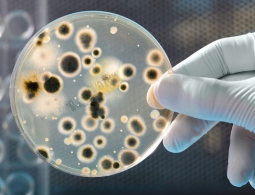
Некоторые бактерии жили в кишечнике человека еще до того, как он стал человеком

Популярные новости
Приглашаем на персональную выставку народного маст...
Будущий мастер-краснодеревщик родился в поселке Дубровка Брянской области. В десять лет впервые познакомился с чудесными запахами дерева, сделав свою первую шкатулку. После окончания школы пошёл работать на Дубровскую мебельную фабрику учеником столяра.Мастер уверен в том, что «дерево обладает волшебной силой, способной внести в душу покой и умиротворение, а жилище наполнить уютом и красотой»:– С годами я выработал свой стиль, сам придумывал и разрабатывал модели мебели...
Украина подсчитала ущерб от потери имущества в Крыму
МОСКВА, 27 июл – РИА Новости. Украинские государственные учреждения потеряли в Крыму имущество на сумму свыше 150 миллионов гривен (400 миллионов рублей). Об этом сообщается на сайте так называемой прокуратуры Автономной Республики Крым, которая входит в состав Генпрокуратуры Украины.Отмечается, что...
Американец инвестировал выигранные в лотерею миллионы в наркоторговлю
МОСКВА, 27 июл — РИА Новости. Житель американского штата Джорджия, выигравший 3 миллиона долларов в лотерею, признал свою вину в финансировании наркодилеров, передает телеканал ABC.Ронни Мьюзик выиграл в лотерею в феврале прошлого года. Он признал свою вину после того, как были предъявлены доказател...
Российский проект 3D-печатного беспилотника приглянулся концерну Airbus
Проект российского дизайнера Алексея Медведева одержал победу в совместном конкурсе Airbus и Local Motors по проектированию грузового беспилотника будущего. Согласно условиям конкурса, дрон должен обладать грузоподъемностью до 5 кг и дальностью до 100 км. Основное предназначение беспилотников заключ...
Нила Ушакова оштрафовали за русскоязычные посты рижской думы в соцсетях
РИГА, 27 июл – РИА Новости. Центр государственного языка оштрафовал мэра Риги Нила Ушакова за то, что Рижская дума использует русский язык для общения в соцсетях."Центр государственного языка все-таки принял решение оштрафовать меня за то, что Рижская дума в социальных сетях (Facebook, Twitter и Ins...
Огласите весь список: зачем россиян внесут в единый реестр
МОСКВА, 27 июл. Наталья Дембинская, обозреватель МИА "Россия сегодня". Создать единый реестр населения – такое поручение премьер России Дмитрий Медведев дал Минсвязи. Уже к осени в министерстве должны разработать концепцию новой базы данных и подготовить соответствующий законопроект. Предполагается...
В Польше нашли документы УПА с призывом убивать женщин и детей
МОСКВА, 27 июл — РИА Новости. Инструкции Украинской повстанческой армии (ОУН-УПА, запрещена в России) с призывами в случае необходимости убивать польских женщин и детей были представлены отделом Института национальной памяти (ИНП) Польши в Люблине, сообщает местное издание Dziennik Wschodni.По данны...
Умная аптечка сама подскажет, какие лекарства нужно принять
Практически у каждого домашняя аптечка представляет из себя обычную коробку, в которой таблетки, бинты и спреи свалены в одну кучу. Зачастую даже без аннотаций по приему медикаментов. Но совсем скоро ситуация может кардинально поменяться, благодаря смарт-аптечке GALE, которая не только поможет в выб...
10 удивительных открытий и научных достижений первой половины 2016 года
Научные открытия, достижения и изобретения происходят постоянно. В течение всего года СМИ балуют нас громкими заголовками и сообщают о новых патентах, однако по-настоящему стоящих открытий за год можно буквально пересчитать по пальцам. Этот год еще не закончился, однако у нас уже набралось 10 очень...
Некоторые бактерии жили в кишечнике человека еще до того, как он стал человеком
Некоторые бактерии в наших кишечниках несут свое тяжкое бремя уже миллионы лет, еще с тех времен, когда мы не были, собственно, человеком. Согласно исследованию, недавно опубликованному в журнале Science, эволюция играет более важную роль во внутреннем микробном составе человека, чем считали ранее....
FT: Россия проводит эффективную оборонительную игру в экономике
МОСКВА, 27 июл — РИА Новости. Непростая ситуация на международной арене не мешает России вести чрезвычайно спокойную и эффективную оборонительную игру на экономическом фронте, пишет Financial Times.Стране пришлось пережить немало проблем в связи с обвалом цен на нефть, и западные эксперты массово пр...
Шойгу рассказал об изменениях в ЮВО в ответ на усиление НАТО и другие риски
МОСКВА, 27 июл — РИА Новости. В связи с наращиванием военного присутствия НАТО в Восточной Европе, ситуацией на Украине и деятельностью международных террористических группировок с 2013 года в Южном военном округе сформированы четыре дивизии, 9 бригад и 22 полка, в том числе созданы две ракетные бри...
Путин пообещал олимпийцам защитить их интересы
МОСКВА, 27 июл — РИА Новости. Президент России Владимир Путин на встрече с олимпийской сборной пообещал сделать все, чтобы отстоять имя российских спортсменов.Глава государства подчеркнул, что Россия не может согласиться с абсолютной дисквалификацией легкоатлетов и будет добиваться правды.Ситуация...